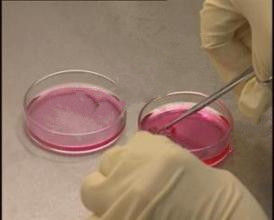
原代培養

簡介
 原代培養
原代培養將動物機體的各種組織從機體中取出,經各種酶(常用胰蛋白酶)、螯合劑(常用EDTA)或機械方法處理,分散成單細胞,置合適的培養基中培養,使細胞得以生存、生長和繁殖,這一過程稱原代培養。
二、儀器、材料及試劑
儀器:培養箱(調整至37℃),培養瓶、青黴素瓶、小玻璃漏斗、平皿、吸管、移液管、紗布、手術器械、血球計數板、離心機、水浴箱(37℃)。
材料:胎鼠或新生鼠。
試劑:1640培養基(含20%小牛血清),0.25%胰酶,Hank’s液,碘酒。
三、操作步驟
(一)胰酶消化法
1.器材:將孕鼠或新生小鼠拉頸椎致死,置75%酒精泡2-3秒鐘(時間不能過長、以免酒精從口和肛門浸入體內)再用碘酒消毒腹部,取胎鼠帶入超淨台內(或將新生小鼠在超淨台內)解剖取組織,置平皿中。
2.用Hank’s液洗滌三次,並剔除脂肪,結締組織,血液等雜物。
3.用手術剪將組織剪成小塊(1mm3),再用Hank’s液洗三次,轉移至小青黴素瓶中。
4.視組織塊量加入5-6倍體積的0.25%胰酶液,37℃中消化20-40分鐘,每隔5分鐘振盪一次,或用吸管吹打一次,使細胞分離。
5.加入3-5ml培養液以終止胰酶消化作用(或加入胰酶抑制劑)。
6.靜置5-10分鐘,使未分散的組織塊下沉,取懸液加入到離心管中。
7.1000rpm,離心10分鐘,棄上清液。
8.加入Hank’s液5ml,衝散細胞,再離心一次,棄上清液。
9.加入培養液1-2ml(視細胞量),血球計數板計數。
10.將細胞調整到5×105/ml左右,轉移至25ml細胞培養瓶中,37℃下培養。
細胞分離的方法各實驗室不同,所採用的消化酶也不相同(如膠原酶,透明質酶等)。
(二)組織塊直接培養法
自上方法第3步後,將組織塊轉移到培養瓶,貼附與瓶底面。翻轉瓶底朝上,將培養液加至瓶中,培養液勿接觸組織塊。於37℃靜置3—5小時,輕輕翻轉培養瓶,使組織浸入培養液中(勿使組織漂起),37℃繼續培養。
四、注意事項
1、自取材開始,保持所有組織細胞處於無菌條件。細胞計數可在有菌環境中進行。
2、在超淨台中,組織細胞、培養液等不能暴露過久,以免溶液蒸發。
3、凡在超淨台外操作的步驟,各器皿需用蓋子或橡皮塞,以防止細菌落入。
五、無菌操作的幾個注意事項
1、操作前要洗手,進入超淨台後手要用75%酒精或0.2%新潔爾滅擦試。試劑等瓶口也要擦試。
2、點燃酒精燈,操作在火焰附近進行,耐熱物品要經常在火焰上燒灼,金屬器械燒灼時間不能太長,以免退火,並冷卻後才能夾取組織,吸取過營養液的用具不能再燒灼,以免燒焦形成碳膜。
3、操作動作要準確敏捷,但又不能太快,以防空氣流動,增加污染機會。
4、不能用手觸已消毒器皿的工作部分,工作檯面上用品要布局合理。
5、瓶子開口後要儘量保持45°斜位。
6、吸溶液的吸管等不能混用。
附:Hank’s液配方:
KH2PO40.06g,Nacl8.0g,NaHCO30.35g,KCl0.4g,葡萄糖1.0g,Na2HPO4·H2O0.06g,加H2O至1000ml。
註:Hank’s液可以高壓滅菌。4℃下保存。
基本介紹
 原代培養
原代培養分類
最常用的原代培養有組織塊培養和分散細胞培養。組織塊培養是將剪碎的組織塊直接移植在培養瓶壁上,加入培養基後進行培養。
分散細胞培養則是將組織塊用機械法或化學法使細胞分散。如欲從胎兒或新生兒的組織分離到活性最好的游離細胞,經典的方法是用蛋白水解酶(如胰蛋白酶和膠原酶)消化細胞間的結合物,或用金屬離子螯合劑(如EDTA)除去細胞互相粘著所依賴的Ca2+,再經機械輕度振盪,使之成為單細胞。
實驗
實驗目的
能獨立地進行細胞的原代培養,爭取原代培養一次成功。
實驗原理
細胞培養是生物學和醫學研究最常用的手段之一,可分為原代培養和傳代培養兩種。原代培養是直接從生物體獲取細胞進行培養。由於細胞剛剛從活體組織分離出來,故更接近於生物體內的生活狀態。這一方法可為研究生物體細胞的生長、代謝、繁殖提供有力的手段,同時也為以後傳代培養創造條件。利用此方法還可直接服務於臨床實踐。例如,用從手術中切除的腫瘤細胞進行原代培養,然後用該培養細胞進行抗癌藥物的篩選,根據腫瘤細胞對加入的化療藥物的敏感性來幫助選擇最有效的化療方案,有可能起到增強療效、降低副作用的作用。原代培養可分為消化法和組織塊培養法,這裡統一作介紹。
實驗材料
材料:培養瓶,青黴素瓶,小玻璃漏斗,三角燒瓶,平皿,吸管,試管,移液管,無菌紗布,無菌眼科剪,廢液缸,血球計數板,蠟盤,手術器械,大頭針,離心管。孕鼠或新生1。4d乳鼠,75%酒精棉球,2%碘酒。
藥品:培養基(RPMI1640或DMEM),小牛血清,0.125%胰蛋白酶,Hanks液,75%酒精,雙抗(青黴素和鏈黴素)。
儀器(請參看儀器圖庫):CO2培養箱.;倒置顯微鏡,超淨台,磁力攪拌器,離心機。
實驗步驟
 原代培養
原代培養2.用Hanks液洗滌3次,剪開子宮取出胚胎。除去子宮、血液和筋膜等組織。
3.用彎頭剪把胚胎儘量剪碎,每個組織塊小於1mm3。在操作時應儘量將平皿蓋半蓋住平皿以防空氣中塵埃落下污染組織。再用Hanks液洗滌2—3次,自然沉澱。用吸管吸去上清液。以下可按兩種方法進行,即消化法和組織塊培養法。
4.若使用消化法,則將組織塊放人三角燒瓶內加入10—30mL0.125%胰蛋白酶,37℃磁力攪拌消化20多min。然後加人少量血清終止消化。用幾層無菌紗布過濾。取過濾液,800r/min離心5-10min收集細胞。棄上清,加入帶有雙抗的培養基,放入培養瓶中培養。
5.若進行組織塊培養,則不做步驟4,加入幾滴血清於組織塊中,再用彎頭吸管將組織塊懸液吸起。在一小培養瓶中逐個鋪展開,注意將瓶底塗抹均勻。將瓶子翻轉倒置後在37℃培養箱內放置2-3h。待組織塊微乾與瓶壁粘牢後再輕輕將瓶子翻轉過來,從邊角加入4-5mL培養基,使細胞接觸到培養基,放培養箱內繼續進行培養。
操作要領
混勻操作要領
(1)火焰消毒吸管,用Hanks液冷卻和濕潤管內壁(這是因為剛分離的組織細胞易粘在管壁上)。
(2)吸管頭插入管底。
(3)用吸管反覆輕輕吹打組織塊。
器械的使用
(1)用工作檯消毒鑷子取浸泡在酒精中消毒的器械。
(2)器械置無菌乾紗布內嚓一下。迅速通過火焰,冷卻後使用。
(3)用過的器械置另一加蓋的器皿中再消毒。
(4)器械按浸泡消毒的順序使用。
(5)各套再消毒器械不可混用。
除去多餘水分
用吸管將組織塊推向青黴素瓶一角,然後將有組織塊的瓶面翻向上方,吸去流向對側的多餘水分。
注意:多餘水分若不除去,會使組織塊剪下不細,消化後的細胞懸液清亮(細胞數少),並可見消化液中有線狀或絮狀物漂浮。
細胞計數
(1)用吸管混勻待計數的細胞懸液。
(2)將一小滴細胞懸液從蓋玻片與載玻片交界部位滴入細胞計數池中。
(3)沉降1分鐘,低倍鏡下計數血球計數板四大中格的結構完整的細胞,小細胞團計數為1。
(4)計數時,如果細胞壓在格上,則數上不數下,數左不數右。然後按下式計算出每毫升懸液中的細胞數。
(四大中格細胞數/4)*10000=細胞數/毫升。
注意事項
原代培養
原代培養1、嚴格進行動物皮膚消毒,使用三套器械取材。新生動物皮膚先用2%碘酒液消毒,成年鼠先用3%~5%碘酒液消毒後用75%酒精消毒。
2、嚴格進行無菌操作,防止細菌、黴菌、支原體污染,避免化學物質污染。
3、吸取液體前,瓶口和吸管進行火焰消毒;吸取液體時,避免瓶口和吸管碰撞。
4、離心管入台前,管口、管壁應消毒。
5、實驗者離開超淨台時,要隨時用肘部關閉工作窗。
6、使用過的器械用酒精棉球擦去血污後,移入另一個器皿中繼續消毒,在浸泡器械時剪刀口要叉開放,鑷子彎頭要向下放,並加蓋消毒。
二、器材使用時既要注意用火焰消毒,又要防止燙傷、燙死細胞。經火焰消毒後的吸管一定要用Hanks液冷卻。
三、超淨台內溫度、濕度較大,在夏天工作時台內散熱更慢,因此進行細胞懸液混勻、接種時,離火焰要稍微遠些。

